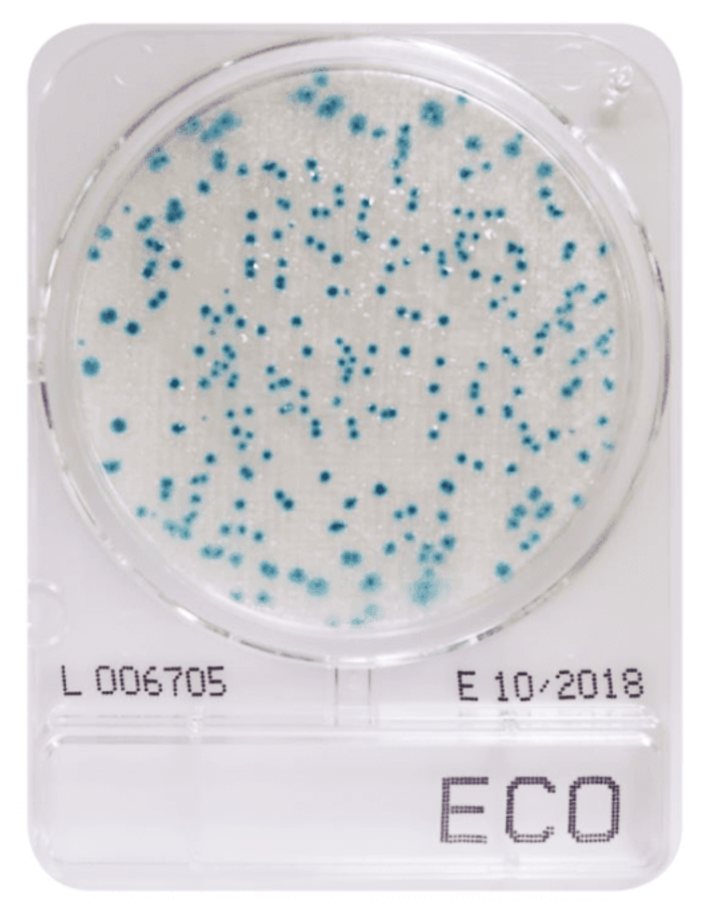
CompactDry ECO (E.coli food & drinks)

CompactDry ECO (coliform): Simple and easy to use diagnostic plate used to detect fecal contamination in food & drinks . The plates are fully certified and meet the highest accreditation.
The plates contain a specially formulated media which resuspends in seconds, and generates a colorimetric readout upon successful target identification.
Instructions: Simply remove lid, add 1 mL of sample to the membrane, assemble lid, invert and incubate for 2-3 days at 30 degrees. Finally, count the number of colonies and colour to determine the colony forming units (CFU) per mL.
Supplied as a pack of 12 units. Store in a cool dark room. Shelf life up to 24 months.
Pack size: 12, 40, 240 or 1400.
Storage: Cool dark room, shelf life up to 24 months.
Barcode: 5061056960569. ST0064.
Delivery: Less than 2 weeks.
Couldn't load pickup availability